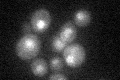
YOL089C
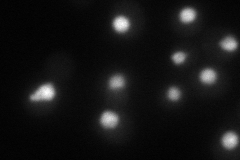
YOL089C
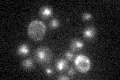
YOL089C

View description
Putative transcription factor containing a zinc finger; overexpression increases salt tolerance through increased expression of the ENA1 (Na+/Li+ extrusion pump) gene while gene disruption decreases both salt tolerance and ENA1 expression
Localization:
Intensity:
Fold change:
Significance:
-
C’ GFP library in SD
nucleus22.23 -
N' NOP1pr-GFP in SD

punctate,nucleus68.4239 -
N' TEF2pr-mCherry in SD
nucleus62.3851 -
N' NATIVEpr-GFP in SD

punctate,nucleus29.873 -
N' TEF2pr-VC and Cyto-VN in SD

#N/A0 -
C’ GFP library in SD+DTT

nucleus21.930.98No -
C’ GFP library in SD+H2O2

nucleus25.521.14No -
C’ GFP library in Starvation Media
nucleus21.350.96No -
C’ GFP library on the background of Pup2-DaMP

nucleus -
C’ GFP library on the background of CCT mutant

nucleus22.65021.0185No
